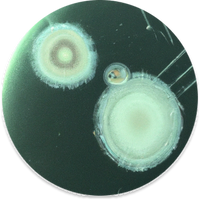

Anaalklieren
🌿 100% natuurlijk 🫙 60 snoepjes
🌿 100% natuurlijk 🫙 60 snoepjes
De slimme keuze bij sleetjerijden en gevoelige anaalklieren.
"Ik streef naar de beste zorg en zie dat DogSuppy werkt. Daarom raad ik het mijn klanten aan."

Anaalklieren
🌿 100% natuurlijk 🫙 60 snoepjes
🌿 100% natuurlijk 🫙 60 snoepjes
De slimme en 100% natuurlijke keuze voor honden met gevoelige anaalklieren. Herken je één of meer van deze signalen?
 "Sleetje rijden" of schuren met de kont
"Sleetje rijden" of schuren met de kont
 Likken rond de anus
Likken rond de anus
 Sterke, visachtige geurtjes die vrijkomen
Sterke, visachtige geurtjes die vrijkomen
Wat maakt dit supplement zo speciaal?
Unieke combinatie van pro-, pre-, para- en postbiotica: Bevordert de darmwerking en helpt de natuurlijke weerstand te versterken.
3,4 Miljard CFU Probiotica per snoepje, afkomstig uit 3 verschillende stammen (Lactobacillus Helveticus, Bacillus Subtilis, Enterococcus Faecium).
100% natuurlijk: Krachtige mix van biotica, aangevuld met zorgvuldig geselecteerde ingrediënten zoals Psyllium en Rode Bietensap. Vrij van kunstmatige kleurstoffen, suikers, granen en gluten.
Getest en vertrouwd: Ontwikkeld door gepassioneerde nutritionisten met meer dan 10 jaar ervaring in dierensupplementen.
Dagelijkse dosering:
Voeg toe aan je bestelling:
- ✓ Inclusief GRATIS verzending
- ✓ 60 dagen tevredenheidsgarantie
- ✓ Besteld voor 22u = morgen geleverd

Transacties zijn 100% beveiligd en versleuteld
Waarom dit werkt
Kan bijdragen aan een comfortabelere stoelgang binnen 3-5 weken
Ondersteunt de natuurlijke werking van de anaalklieren via de darmen
Aanbevolen door dierenartsen
60 dagen om het zelf te ervaren, anders geld terug
100% natuurlijk, zonder granen of gluten
Ontwikkeld door nutritionisten met 10+ jaar ervaring
Herken jij dit bij je hond?
"Sleetje rijden" of met de kont over de grond schuren
Overmatig likken of krabben rond de staart
Inconsistente ontlasting
Sterke, visachtige geurtjes
Onrustig zitten of moeite met zitten
Hoe het werkt
Wat zit erin




Dosering
Onze belofte

Anaalklieren Probiotica Forte 🌿 60 snoepjes
60 dagen geld-terug-garantie
Herken je deze signalen bij je hond?
- "Sleetje rijden" of met de kont over de grond schuren
- Overmatig likken of krabben rond de staart of anus
- Inconsistente ontlasting
- Sterke, visachtige geurtjes die vrijkomen
- Gevoeligheid bij de anus
Hoe ontstaat een verstopping van de anaalklieren?
Wanneer honden poepen, worden hun anaalklieren deels geleegd. Als dit niet goed gebeurt, kunnen de anaalklieren verstopt raken. Dit leidt tot likken en krabben rond de anus en 'sleetje rijden' over de vloer. Ook kunnen sterke, visachtige geurtjes vrijkomen. Kleine honden hebben een grotere kans op problemen omdat ze een kleinere buis hebben waar het vocht doorheen moet passeren.
Veelvoorkomende oorzaken van verstopte anaalklieren:
- Genetische redenen (kleinere honden zijn vatbaarder voor problemen)
- Een onevenwichtige darmgezondheid of overvloed aan ongewenste bacteriën in de darmen
- Een gebrek aan vezels in het dieet
- Onregelmatige ontlasting (te slap of te hard)
Hoe ondersteuning bieden bij verstopte anaalklieren?
Een goede darmflora en spijsvertering staan rechtstreeks in verband met de werking van anaalklieren bij honden. Daarom bestaat ons Anaalklieren supplementen uit:
- Pro-, pre-, para- én postbiotica: Unieke mix die een goede darmwerking ondersteunt en een gezonde darmflora bevordert
- Psyllium: Een natuurlijke vezel die de spijsvertering ondersteunt, voor een consistente ontlasting
- Rode bietensap: Ondersteunt de lever en helpt bij de afvoer van ongewenste stoffen
Waarom kiezen baasjes voor Anaalklieren Probiotica Forte?
✓ Unieke combinatie van pre-, pro-, para- en postbiotica
✓ De meeste klanten zien binnen 3 tot 5 weken positieve veranderingen
✓ Goed voor de darmflora en ondersteunt de spijsvertering
✓ Stimuleert een natuurlijke leging van de anaalklieren
✓ 3,4 Miljard CFU Probiotica per snoepje
✓ Geschikt voor langdurig gebruik
✓ Smakelijke chewies
Bestel nu en ondersteun het dagelijkse comfort van de anaalklieren van je hond, op natuurlijke wijze.
De ingrediënten in DogSuppy-producten zijn zorgvuldig gekozen en in optimale hoeveelheden toegevoegd om ondersteuning te bieden. Houd er echter rekening mee dat natuurlijke ingrediënten het welzijn van je hond van binnenuit ondersteunen, waardoor het even kan duren voordat je zichtbare veranderingen opmerkt.
Het effect kan verschillen per hond en situatie en bij de ene hond is het verschil sneller zichtbaar dan bij de andere. We raden steeds aan om de supplementen 60 dagen tijd te geven, zodat ze grondig hun werk kunnen doen. De eerste veranderingen gebeuren immers inwendig en zijn daarom vaak niet meteen zichtbaar.
Daarom bieden we – als een van de weinige merken in Nederland en België – een tevredenheidsgarantie van 60 dagen op je eerste bestelling aan. Je hebt dus een periode van twee maanden om zelf te ontdekken hoe dit supplement kan bijdragen aan het welzijn van je hond.
Merk je binnen 60 dagen toch geen verschil?
Stuur dan een e-mail naar support@dogsuppy.com, wij zijn elke dag bereikbaar, zélfs op zon- en feestdagen.
Dit 100% natuurlijk supplement bevat geen gluten, granen, suikers of kunstmatige kleurstoffen en is ontwikkeld door gepassioneerde nutritionisten met meer dan 10 jaar ervaring in dierensupplementen. We gebruiken uitsluitend grondstoffen die voldoen aan de Europese regelgeving.
Bovendien gebruiken wij een"cold-pressed" techniekbij de productie van onze supplementen. Hoewel sommige producenten een productie tussen 45 to 80ºC ook als cold pressed beschouwen, gaan wij hierin nog een stap verder en gaan onze temperaturen nooit hoger dan 38ºC. Omdat wij de temperaturen zo laag houden, blijven meer goede bacteriën intact, waardoor het supplement zijn kracht beter behoudt.
Hoofdingrediënten Pre - Probiotica, Psyllium, Diamond V, L-Carnitine
Voedermiddelen: aardappelproduct, insectenmeel, glycerine, gist (12.1.5), gist & delen daarvan, rode bietensap, plantaardige olie, psyllium, cichoreiwortelpoeder, erwtenmeel, cranberry, calcium, pectine, lactobacillus Helveticus HA-122
Toevoegingsmiddelen: L-Carnitine, Vitamine B1, Vitamine B2, Riboflavine, Calcium - D - Pantothenaat, Vitamine B6, Pyridoxine Hydrochloride, Vitamine B12, niacinamide, Zinc Chelate of Glycine Hydrate (solid) - Zinc, L-Glutamine, Clinoptilolite from sedimenary origin, Bacillus Subtilis, Mengsel van aromatische stoffen, Acacia Gum & Enterococcus Faecium.
🐾 Geschikt voor honden vanaf 3 maanden.
Het aantal chewies hangt af van het gewicht van je hond. Voor een optimale werking geef je Anaalklieren Probiotica Forte als volgt - chewies volgens lichaamsgewicht van je hond:
- 0 tot 10 kg: 1 snoepje per dag
- 10 tot 20 kg: 2 chewies per dag
- Vanaf 20 kg: shop onze GroteHond⁺ potten Anaalklieren op maat van honden > 20 kg
Wat bij meerdere chewies?
Meerdere chewies mag je -als je hond dat fijn vindt- in 1x geven.
Wanneer geven:
Indien mogelijk mag je de chewies ‘s morgens geven op een nuchtere maag.
Vindt je hond dat niet fijn? Meng ze dan met het vast voer of iets lekkers, of verdeel de chewies over de dag.
Wat als ik meerdere supplementen geef?
Elk supplement bevat andere werkzame stoffen om in te werken op een specifiek probleem.
Hou daarom de aanbevolen chewies per variant aan.
🫙 1 pot bevat 180g Anaalklieren Probiotica Forte (± 60 chewies)
🐾 Geschikt voor honden vanaf 3 maanden.

Ontmoet onze Woef Managers
Ons team enthousiaste hondenspecialisten staat steeds klaar om hulp te bieden bij jouw vragen, opmerkingen of twijfels. En dat 7/7, ook tijdens het weekend en op feestdagen!
Veelgestelde vragen over Anaalklieren Probiotica Forte
→ Kies voor Anaalklieren Probiotica Forte:
Als je hond alleen last heeft van darmproblemen zoals onregelmatige ontlasting, winderigheid of een verstoorde stoelgang én gevoeligheden aan de anaalklieren. Hoe kan je dit merken:
- "Sleetje rijden" of met de kont over de grond schuren
- Overmatig likken of krabben rond de staart of anus
- Sterke, visachtige geurtjes die vrijkomen
- Gevoeligheid bij de anus
→ Kies voor Probiotica Forte:
Als je hond alleen last heeft van darmproblemen zoals onregelmatige ontlasting, winderigheid of een verstoorde stoelgang.
- Met 3,4 miljard CFU probiotica per snoepje, afkomstig uit 3 verschillende stammen (Lactobacillus Helveticus, Bacillus Subtilis, Enterococcus Faecium), en met toevoeging van prebiotica en postbiotica, is dit de meest complete en geconcentreerde probiotica die verkrijgbaar is in België en Nederland.
We kiezen bewust om de probiotica te combineren met prebiotica, waardoor we dus niet alleen de goede bacteriën toevoegen, maar ook de voeding voor de goede bacteriën. - Naast de pre- en probiotica worden er nog extra grondstoffen zoals Psyllium en Rode bietensap toegevoegd om het legen van anaalklieren extra te stimuleren.
- Daarnaast zijn we door duizenden hondenbaasjes in beoordeeld als nummer 1 supplement in Nederland en België op Trustpilot. Daar zijn we onze trouwe klanten ontzettend dankbaar voor.
De meeste hondenbaasjes geven aan dat ze na 3-5 weken verbetering zien, bij sommige duurt het iets langer tot 6-8 weken. De natuurlijke ingrediënten ondersteunen je hond van binnenuit, waardoor het even kan duren voordat je zichtbare veranderingen opmerkt.
We bieden een uitgebreide geld-terug-garantie van 60 dagen, zodat je voldoende tijd hebt om de positieve effecten te ervaren.
Het aantal chewies hangt af van het gewicht van je hond. Voor een optimale werking geef je Anaalklieren Probiotica Forte als volgt - chewies volgens lichaamsgewicht van je hond:
- 0 tot 10 kg: 1 snoepje per dag
- 10 tot 20 kg: 2 chewies per dag
- Vanaf 20 kg: shop onze GroteHond⁺ potten Anaalklieren op maat van honden > 20 kg
Wat bij meerdere chewies?
Meerdere chewies mag je -als je hond dat fijn vindt- in 1x geven.
Wanneer geven:
Indien mogelijk mag je de chewies ‘s morgens geven op een nuchtere maag.
Vindt je hond dat niet fijn? Meng ze dan met het vast voer of iets lekkers, of verdeel de chewies over de dag.
Wat als ik meerdere supplementen geef?
Elk supplement bevat andere werkzame stoffen om in te werken op een specifiek probleem.
Hou daarom de aanbevolen chewies per variant aan.
🫙 1 pot bevat 180g Anaalklieren Probiotica Forte (± 60 chewies)
🐾 Geschikt voor honden vanaf 3 maanden.
Je kan onze supplementen het best bewaren op een koele, droge en donkere plaats, weg van direct zonlicht (hoeft niet in de frigo).
Het kan zijn dat je hond in het begin even moet wennen aan de chewies. Maar geen zorgen, we hebben hier een paar handige tips voor!
- Meng de chewies met iets wat je hond heel lekker vindt, zoals paté, smeerkaas of een andere traktatie.
- Verkruimel de chewies eerst door het voer van je hond.
Als dat niet helpt, kun je altijd gebruikmaken van onze 60 dagen tevredenheidsgarantie. Je krijgt dan het volledige bedrag terug, zonder gedoe.
Dit 100% natuurlijk supplement is ontwikkeld door gepassioneerde nutritionisten met meer dan 10 jaar ervaring in dierensupplementen. We gebruiken uitsluitend grondstoffen die voldoen aan de Europese regelgeving.
Onder “Alle ingrediënten” vind je een volledige lijst van alle ingrediënten. Heeft je hond bepaalde voedingsallergieën of twijfel je over een ingrediënt? Stuur dan gerust een e-mail naar support@dogsuppy.com, we helpen je graag.
Onze supplementen zijn vrij van gluten, granen, suikers of kunstmatige kleurstoffen en zijn ontwikkeld door gepassioneerde nutritionisten met meer dan 10 jaar ervaring in dierensupplementen. We gebruiken uitsluitend grondstoffen die voldoen aan de Europese regelgeving.
Ja. Dit supplement is op basis van insectenmeel en bevat geen vlees.
Onze Anaalklieren Probiotica Forte is geschikt voor honden vanaf 3 maanden.
Ja, onze producten zijn 100% natuurlijk en bevatten geen kunstmatige kleurstoffen. We gebruiken uitsluitend grondstoffen die voldoen aan de Europese regelgeving.
We raden sterk aan om de eerste 2 maanden iedere dag de supplementen te geven om de positieve effecten te zien. Daarna hangt het van situatie tot situatie af.
Meestal hebben honden er echt baat bij om de supplementen als blijvende aanvulling op hun dagelijkse dieet te blijven krijgen. Dit zorgt voor een fijne, blijvende ondersteuning in de routine van je hond. Omdat we met 100% natuurlijke ingrediënten werken, kun je dit zonder zorgen langdurig geven (het is geen medicijn).
Zeker. Elk product bevat specifieke werkzame stoffen, waardoor het nuttig kan zijn om verschillende producten in te zetten. Wij raden aan om de aanbevolen chewies per variant aan te houden.
Op onze bundels-pagina kan je verschillende voordelige bundels terugvinden, zo kan je genieten van een voordelige prijs op een combinatie van supplementen.
Onze formules zijn zorgvuldig ontwikkeld voor honden, daarom raden we ze niet aan voor katten.